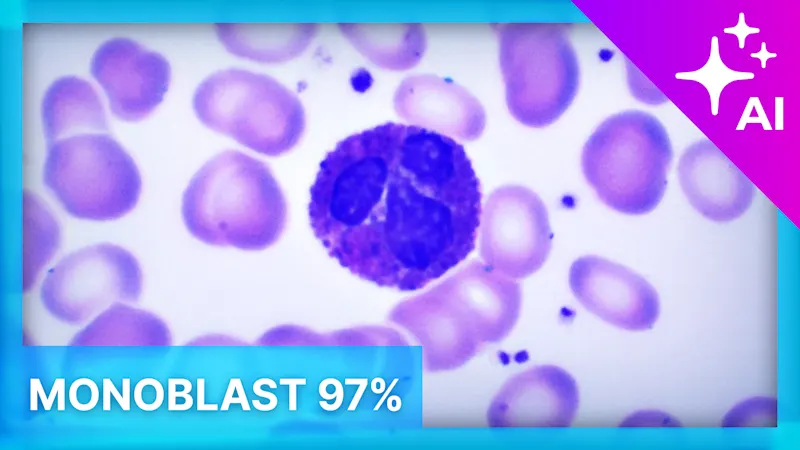

The efficient AI software for image analysis
With its deep learning algorithms, pylon AI enables complex image analysis such as object detection or segmentation. Unique to computer vision software, the new performance benchmarking feature allows users to determine the most powerful processing hardware for their application. pylon AI can be used by anyone without any programming.
Maximize the performance of your AI application
Benchmark the performance of your AI model across a range of processors and AI chips
Optimize your AI model for vision applications
Optimize your AI model for your processing hardware and enhance the AI vTool's specific algorithm
Simple: no programming
Create image analysis functions with drag-and-drop ease and deploy them to target applications using proven pylon APIs
Flexibility thanks to ONNX AI model format
Whether your AI model is trained in PyTorch, TensorFlow, or NVIDIA TAO – pylon AI is compatible with a wide range of AI frameworks
pylon AI: new applications, precise and fast
In contrast to traditional algorithms, the algorithms of modern AI systems are constantly learning. This enables new and complex use cases. At the same time, the probability of errors decreases and the readout speed increases, making your application faster and more precise.

Object detection
Locating and counting different and complex objects in the image.
Classification
Classification and systematic grouping of objects and live images into categories.

Anomaly Detection
Identifying unusual patterns and deviations from expected attributes.

Semantic segmentation
Identification of pixel clusters to distinguish object classes and background regions in the image with pixel accuracy.

Instance segmentation
Prediction of pixel-accurate boundaries of each individual object in the image.

AI-based OCR
Intelligent text recognition under difficult and changing readout conditions.